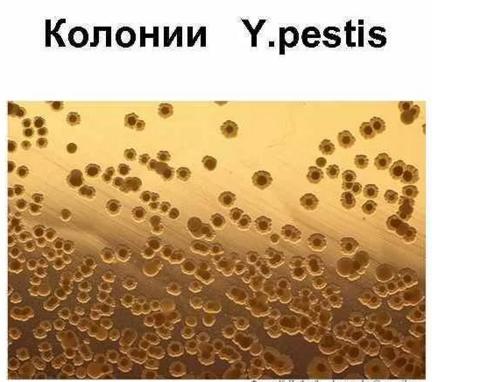

Куды бечь? Капитализм vs социализм, часть 46
Предыдущая часть темы: Куды бечь? Капитализм vs социализм, часть 46
Клуб Степняка |
Привет, Гость! Войдите или зарегистрируйтесь.
Вы здесь » Клуб Степняка » Куды бечь? Капитализм vs социализм » Куды бечь? Капитализм vs социализм, часть 46 #2
Куды бечь? Капитализм vs социализм, часть 46
Предыдущая часть темы: Куды бечь? Капитализм vs социализм, часть 46
а дядя 57-ми лет отшельник, что-то у него не сложилось, о чем он сам "уклончиво объяснил", с тех пор не выезжая он говорит, что от Калининграда до Владивостока все живут как он, с 13-тью телятами, солнечными панелями, компьютером, трактором, и в рубищах.
но ведь это проблемы "дяди" 
То есть цифр не будет. Поздравляю Вас, господин соврамши.
https://minfin.gov.ru/ru/search/?q_4=внешний долг&source_id_4=6
Может он просто не вписался в рынок?
Точно. 
Victor72 написал(а):То есть цифр не будет. Поздравляю Вас, господин соврамши.
https://minfin.gov.ru/ru/search/?q_4=внешний долг&source_id_4=6
Он о другом. Он про закредитованность. Она в России примерно 30 процентов от доходов граждан. То есть граждане закредитованы на 30 процентов своих максимальных возможностейпо выплатам. Есть мнение, что при нынешней, сложной экономической ситуации это уже близко к пределу.
При этом развитие самой ситуации не рассматривается. Закредитованность может уменьшаться, экономика, наоборот, развиваться, об этом разговора не было.
Было обычное, "Скоро вам хана! Путина геть!"
Степняк, позвольте не по теме. Я припоминаю был разговор о том, что вируса СПИД на самом деле не существует. То есть вот так вот я тот разговор понял. Не смогли бы вы уточнить как обстоит дело на самом деле. Есть этот вирус, нет его?
Я спрашиваю потому, что разработчик вакцины пфайзер в интервью своем сослался на этот вирус СПИД. Сказав, что коронавирус якобы мутирует также "успешно". Что в этот и состоит главная проблема борьбы, как со СПИД, так и с коронавирусом.
Прокомментируйте если не трудно.
Мнения ученых расходятся : одни считают ,что он есть, другие считают, что его ,как отдельного инфекционного возбудителя, не существует. Я отношусь ко вторым, и вместе со многими коллегами полагаю, что СПИД (синдром приобретенного иммунодефицита человека) вызывают самые разные и разнообразные вирусы. А предъявляемые электронные фотографии и расшифрованные ДНК-последовательности вируса ВИЧ являются только отображениями некоторых таких вирусов ,попадание которых в человеческий организм вызывает иммунодефицит.
Мда, так вот...
Когда проводят поиск возбудителя какого-либо заболевания , проводят несколько этапов его "верификации".
Ну скажем для возбудителя чумы ( хотя это не вирус, а бацилла , т.е. палочковидная бактерия , способная образовывать своеобразные споры - капсулы) сначала у больных, или трупов людей и животных, или из объектов внешней среды , берут мазки/отпечатки и высевают их на питательные среды - жидкие бульонные и/или плотные агаровые.
Вырастает там всякое, особенно если исходным материалом являются полуразложившиеся останки

но среди выросшего на плотных питательных средах "зоопарка" достаточно легко обнаруживаются характерные колонии чумного микроба, которые проходят три стадии :
1) "битого стекла" ; 2) "кружевных платочков" и 3) "ромашек" (ну это потому что микроб уже хорошо изучен , и мы знаем, на что обратить внимание)
Забирают бактериологической петлей материал только из нужной колонии, пересевают его дальше и в конце концов получают чистую культуру, т.е. состоящую только из колоний чумного микроба :
Потом идет этап бактериологической идентификации по микроскопии мазков и характерным биохимическим свойствам, определяемым на специальных питательных средах или приборами, подробности которого мы опускаем.
После этого начинается этап "проверки", действительно ли именно этот выделенный микроб вызывает чуму ? Из выделенных колоний делается взвесь и она вводится подопытным животным, которые через некоторое врем должны помереть с характерной клинической картиной. После этого животных вскрывают, берут мазки из самых поражаемых органов - лимфоузлов, легких, сердца, печени , делают отпечатки на предметных стеклах для микроскопии, делают посевы всех этих фрагментов на питательные среды, проводят тот же цикл пересевов и на выходе снова получают такого же вида колонии на чашке Петри. Иногда задействуют электронную микроскопию (просвечивающую или сканирующую) , постановку иммунологических реакций (гемагглютинацию, преципитацию в геле, и .т.п) , иммунохимическое окрашивание специфическими антительными препаратами и сыворотками с метками (иммунолюминесцентный анализ, иммуноферментный, радиоиммунный , хемилюминесцентный , и .т.д.)
Короче говоря , проводят кучу манипуляций , чтобы убедиться , что выделен именно чумной микроб, а не какой-то другой, и что именно он при введении его биопробным животным вызовет у них характерную картину заболевания и смерть в достаточно короткие сроки - от 24 до 120 часов.
С хорошо изученными вирусами (гриппа, оспы, и т.д.) примерно такая же метода : выделение, визуализация, получение чистой культуры, заражение животных , их болезнь и выделение чистой культуры уже от болеющих или переболевших животных.
А вот с вирусами, вызывающими СПИД , т.е. синдром приобретенного иммунодефицита , ситуация сложнее...
И эти сложности определяются двумя основными факторами : 1) возникновением иммунодефицитов у человека и животных после практически ЛЮБЫХ вирусных заболеваний 2) длительностью развития болезни.
И вот к чему это приводит.
Допустим у нас имеется "нулевой" пациент с выраженным иммунодефицитом, т.е. СПИД налицо. Начинаете брать анализы и пробы - находите в организме с полдюжины незнакомых вирусов : их -то в окружающей среде - пруд-пруди. Как же проверить то это или не то ? Биопробами проверить практически невозможно из-за сроков. Заразили сегодня , а клиническая картина иммунодефицита проявится через много лет , причем за эти годы подопытный может нахватать "с улицы" других вирусов, которые сами по себе вызывают иммунодефицит. И как же в этом случае узнать был ли первый вирус именно тем самым вирусом иммунодефицита ЧЕЛОВЕКА ? Да никак !
Практически ЛЮБОЙ вирус (тех же гепатитов, герпеса, разные вирусы гриппа, разные коронавирусы , и т.д.) могут привести к возникновению стойких прогрессирующих иммунодефицитов ) , что наглядно демонстрирует классификация ВИЧ в википедийной статье :
ВИЧ-1
ВИЧ-1 описан в 1983 году и является наиболее распространённым и патогенным видом ВИЧ[87]. Глобальная эпидемия ВИЧ-инфекции главным образом обусловлена распространением ВИЧ-1. В подавляющем большинстве случаев, если не оговорено иначе, под ВИЧ подразумевают ВИЧ-1[88].
Вид ВИЧ-1 классифицируют на главную группу М и несколько побочных групп. Считается, что группы M, N, O, P образовались в результате независимых случаев передачи SIV от обезьяны к человеку, и последующей мутации вируса до ВИЧ[89].
Вирусы группы М (англ. main — основная) являются причиной более 90 % случаев ВИЧ-инфекции. Группу М классифицируют на несколько клад, называемых подтипами, также обозначаемых буквами:
подтип A широко распространён, например, в Западной Африке и России[90];
подтип B доминирует в Европе, Северной Америке, Южной Америке, Японии, Таиланде, Австралии[91];
подтип C преобладает в Южной и Восточной Африке, Индии, Непале, некоторых частях Китая[91];
подтип D обнаружен только в Восточной и Центральной Африке[91];
подтип E не был выявлен в нерекомбинантном виде, лишь совместно с подтипом А как CRF01_AE в Юго-Восточной Азии[91];
подтип F выявлен в Центральной Африке, Южной Америке и Восточной Европе[92];
подтип G и рекомбинантная форма CRF02_AG выявлены в Африке и Центральной Европе[92];
подтип H обнаружен только в Центральной Африке[92];
подтип I был предложен для описания штамма-продукта множественной рекомбинации CRF04_cpx нескольких подтипов[93];
подтип J распространён в Северной, Центральной и Западной Африке и странах Карибского бассейна[94];
подтип K обнаружен только в Конго и Камеруне[92].
подтип L обнаружен в Конго.[95]
Группа O (англ. outlier — непохожий) обнаружена в Центральной Африке и Западной Африке. Наиболее распространена в Камеруне, где в 1997 году более 2 % пациентов были заражены вирусом группы О[96] (около 100 000 человек, по данным на 2013 год)[97]. Вирусы этой группы не определялись ранними версиями тест-систем на ВИЧ-1; современные тесты определяют вирусы и группы О, и группы N[98].
Группа N (англ. non-M, non-O — ни M, ни O) обозначает штаммы не М и не О, описана в 1998 году и обнаружена только в Камеруне. С 2006 года выявлены лишь 10 заражений вирусами группы N[99].
Группа P — в 2009 году была определена нуклеотидная последовательность РНК ВИЧ, значительно сходная с вирусом иммунодефицита обезьян, описанным у горилл (SIVgor), но не с SIV, характерным для шимпанзе (SIVcpz). Вирус был выделен из образцов, полученных от женщины камерунского происхождения, проживающей во Франции[100][101][102].ВИЧ-2
ВИЧ-2 идентифицирован в 1986 году[103], генетически очень близок к T-лимфотропному вирусу SIVsmm мангабеев, и в меньшей степени к вирусу ВИЧ-1. Геномы ВИЧ-1 и ВИЧ-2 имеют гомологию консервативных генов gag и pol около 60 %, и до 45 % генов белков оболочки[104]. По состоянию на 2010 год, описано 8 групп ВИЧ-2, лишь группы A и B являются эпидемическими. Вирусы группы А распространены в Западной Африке, Анголе, Мозамбик, Бразилии, Индии и мало распространены в США и Европе[105][106]. Вирусы группы В распространены в Западной Африке
И что мы видим ? Два основных "вида" - ВИЧ-1 и ВИЧ-2, а внутри видов - десятки групп и подгрупп , вирусы которых отличны друг от друга !
Ну то есть мы имеем бездонную бочку с вирусами, из которых все более совершенствующимися методами идентификации, к которым в последние 30-40 лет добавились широко используемые молекулярно-биологические методы с установлением полной последовательности ДНК. Ну и соответственно , теперь , используя эти новые методические подходы, можно каждый год , каждый месяц и даже каждый день выявлять новые "уникальные" вирусы ,которые в той или иной степени будут вызывать у людей и животных иммунодефициты.
После чего проводить соответствующую пиар-кампанию и выбивать гранты и/или бюджетное финансирование на тот вирус "иммунодефицита" , который тебе удалось выделить и поддерживать в культуре. Соответственно появятся новые красивые фотографии, модели, картинки, новые отличающиеся между собой последовательности ДНК, и т.п.



и т.д., и т.п.
Бабки-то под это можно получить ... И получают ... Несхожесть результатов в разных руках можно будет объяснить либо появлением/открытием нового вида либо "мутацией" .
Под "новинку" можно за деньги наделать новых диагностикумов, вакцин, средств профилактики и лечения, и т.п.
И морочить всем этим голову обывателям и "власть+деньги"имущим до морковкиного заговения ....
Да можно с уверенностью сказать, что ВИЧ (вирусЫ иммунодефицита человека) существуют и приводят к серьезным осложнениям и смерти от других инфекций , с которыми самостоятельно справиться организм человека с иммунодефицитом не может. Но вот стратегия профилактики, а главное - лечения СПИД/ВИЧ вызывает у меня и многих моих коллег большие сомнения. Это скорее выглядит как проект обогащения фармацевтической и медицинской мафии массовым продолжительным лечением хроников дорогостоящими препаратами , нежели вменяемая стратегия борьбы с напастью, чтобы ее победить, как ,скажем , это было с испанкой или натуральной оспой.
Примерно все то же самое можно сказать и о нынешнем коронавирусе с его мутантами. Да, он существует. Да, он может дать серьезные осложнения, Да он может убить.
Но что-то тут явно нечисто . Нашествия новых вирусных инфекций и массовых вирусных эпидемий стали регулярно трясти человечество именно после того, как развитие молекулярно-биологических методов позволило СОЗДАВАТЬ вирусы в большом разнообразии ПОД ЗАКАЗ.
Достаточно взглянуть на хронологию , исключив из нее бактериальные инфекции : https://ru.wikipedia.org/wiki/Список_эп … и_пандемий
И особо внимательно взглянув на опасные и крупные эпидемии/пандемии после 1975 года , когда появились возможности вмешательства в структуру ДНК , сначала довольно грубые, а теперь - практически неограниченные : геном вируса можно сконструировать на бумаге/компьютере, а потом этот вирус с заданным геномом создать, синтезировав ДНК или РНК с заданной последовательностью.
Смотрим.
ОТ эпидемии испанского гриппа 1918-1920 до эпидемии азиатского H2N2 о прошло 40 лет
От азиатского до гонконского H3N2 - 20 лет
От гонконгского до "русского" (хотя хрен он "русский", это тот же гонконгский H3N2 , вероятно занесенный в СССР диверсионным путем) - 25 лет
А потом понеслось :
Грипп - 1995-1996
Лихорадка Марбурга - 1998-2000
SARS, SARS-CoV - 2002-2003
Птичий грипп, H5N1 -2004-2019
Грипп - 2004-2005
Свиной грипп, H1N1 - 2009-2010
Вирус Зика 2009
Лихорадка Эбола 2014-2016
Вирус Зика 2015-2016
Лихорадка Эбола 2018-2020
Коронавирус, COVID-19 - с 2019-по настоящее время с многочисленными "мутациями" и угрозами/обещаниями появления новых мутаций и новых вирусов.
К этому еще следует присовокупить вирусную африканскую чуму свиней, которой под эгидой Пентагона стала заниматься Грузия с 2004 года, и которая с 2007 года начала распространяться по югу России , особенно после поражения Грузии в войне 080808. Да еще вирусные гепатиты А и С , которым теперь занимаются в центре Лугара в Грузии и в трех лабораториях из 14 созданных на Украине.
В общем, "это ж-ж-ж - неспроста" (С).
Геномы возбудителей бактериальных и прочих невирусных инфекций устроены сложнее, хуже изучены, и морочиться с их созданием - долго и дорого, а способы противодействия этим инфекциям - довольно хорошо разработаны. Большой выгоды для франкенштейнов не просматривается.
А вот конструировать вирусы с их простыми геномами на основе уже известных патогенных вирусов - проще. А лечение вирусных заболеваний разработано хуже.
Вот и стали появляться и появились, как грибы, сотни американских биологических лабораторий по всему миру, в которых в основном вирусными заболеваниями и занимаются, при полном нарушении Конвенции о биологическом оружии
И на кого эти лаборатории работают - на Пентагон в интересах террористического государства США или же на Гейтса с Соросом из кружка американских глобалистов - непонятно... Скорее - на вторых.
— Все уезжают из деревень, мы остаемся одни. А куда деваться? И чем заниматься, если нет ни работы, нет ничего вообще? Вот трактор есть, но это для себя — сено покосить коровам, — обреченно разводит руками Юрий.
— Трактор — такая техника нужна. Может, в соседних деревнях кому помочь надо?
— Нет здесь населения, кому это надо? Не в Предтурье (поселок Восточный в 16 километрах) же ехать пахать? Там своя техника. А Кошай (село в 20 километрах) еще дальше. И там тоже свои трактора. Здесь последние пенсионеры доживают свое. Такая хрень у нас везде от Калининграда до Владивостока...
Да уж ладно.
В Калининграде даже в дальних поселках куча людей шастает. Бум покупок недвижимости... народ рванул из-за ковида отдыхать.
А вообще, в Канаде куча мест без людей....... Там населения меньше, чем в России... всего 30млн где-то
Интересно..... а в Австралии много деревень? Там всё-таки кенгуру есть.

Мероприятие в Исаакиевском соборе стало поводом для разбирательства

Министр обороны России Сергей Шойгу привлек к дисциплинарной ответственности военачальников Западного военного округа, по решению которых военнослужащих роты почетного караула направили для участия в церемонии венчания потомка династии Романовых.
"По данному факту проведено служебное разбирательство, в результате которого установлены нарушения отдельными должностными лицами требований руководящих документов. Привлечение военнослужащих роты почетного караула к мероприятиям регламентировано нормативными правовыми актами Минобороны", – цитирует РИА Новости источника в Минобороне.
Венчание потомка Романовых Георгия Михайловича и итальянки Ребекки Беттарини прошло в Исаакиевском соборе в Санкт-Петербурге 1 октября. У входа на торжество молодоженов встретили гвардейцы Преображенского полка.
Да уж ладно.
В Калининграде даже в дальних поселках куча людей шастает. Бум покупок недвижимости... народ рванул из-за ковида отдыхать.А вообще, в Канаде куча мест без людей....... Там населения меньше, чем в России...
Интересно..... а в Австралии много деревень? Там всё-таки кенгуру есть.
Канада и Австралия тоже при этом за охулиард рублей посылает актрис в космос киношку снимать?
Он о другом. Он про закредитованность. Она в России примерно 30 процентов от доходов граждан. То есть граждане закредитованы на 30 процентов своих максимальных возможностейпо выплатам. Есть мнение, что при нынешней, сложной экономической ситуации это уже близко к пределу.
При этом развитие самой ситуации не рассматривается. Закредитованность может уменьшаться, экономика, наоборот, развиваться, об этом разговора не было.
Было обычное, "Скоро вам хана! Путина геть!"
А Капри говорил, что есть мнение среди американцев, что жить в кредит -- это нормально.

Канада и Австралия тоже при этом за охулиард рублей посылает актрис в космос киношку снимать?
Нет не посылает.
Они даже космонавтов послать не могут ни своих, ни не своих.

механик написал(а):Степняк, позвольте не по теме. Я припоминаю был разговор о том, что вируса СПИД на самом деле не существует. То есть вот так вот я тот разговор понял. Не смогли бы вы уточнить как обстоит дело на самом деле. Есть этот вирус, нет его?
Я спрашиваю потому, что разработчик вакцины пфайзер в интервью своем сослался на этот вирус СПИД. Сказав, что коронавирус якобы мутирует также "успешно". Что в этот и состоит главная проблема борьбы, как со СПИД, так и с коронавирусом.
Прокомментируйте если не трудно.
Мнения ученых расходятся : одни считают ,что он есть, другие считают, что его ,как отдельного инфекционного возбудителя, не существует. Я отношусь ко вторым, и вместе со многими коллегами полагаю, что СПИД (синдром приобретенного иммунодефицита человека) вызывают самые разные и разнообразные вирусы.
свернутый текстА предъявляемые электронные фотографии и расшифрованные ДНК-последовательности вируса ВИЧ являются только отображениями некоторых таких вирусов ,попадание которых в человеческий организм вызывает иммунодефицит.
Мда, так вот...
Когда проводят поиск возбудителя какого-либо заболевания , проводят несколько этапов его "верификации".
Ну скажем для возбудителя чумы ( хотя это не вирус, а бацилла , т.е. палочковидная бактерия , способная образовывать своеобразные споры - капсулы) сначала у больных, или трупов людей и животных, или из объектов внешней среды , берут мазки/отпечатки и высевают их на питательные среды - жидкие бульонные и/или плотные агаровые.
Вырастает там всякое, особенно если исходным материалом являются полуразложившиеся останки
https://medkarta.com/pic/md/20101703094423.jpg
но среди выросшего на плотных питательных средах "зоопарка" достаточно легко обнаруживаются характерные колонии чумного микроба, которые проходят три стадии :
1) "битого стекла" ; 2) "кружевных платочков" и 3) "ромашек" (ну это потому что микроб уже хорошо изучен , и мы знаем, на что обратить внимание)Забирают бактериологической петлей материал только из нужной колонии, пересевают его дальше и в конце концов получают чистую культуру, т.е. состоящую только из колоний чумного микроба :
https://upforme.ru/uploads/001a/1f/30/2/344334.jpg
Потом идет этап бактериологической идентификации по микроскопии мазков и характерным биохимическим свойствам, определяемым на специальных питательных средах или приборами, подробности которого мы опускаем.
После этого начинается этап "проверки", действительно ли именно этот выделенный микроб вызывает чуму ? Из выделенных колоний делается взвесь и она вводится подопытным животным, которые через некоторое врем должны помереть с характерной клинической картиной. После этого животных вскрывают, берут мазки из самых поражаемых органов - лимфоузлов, легких, сердца, печени , делают отпечатки на предметных стеклах для микроскопии, делают посевы всех этих фрагментов на питательные среды, проводят тот же цикл пересевов и на выходе снова получают такого же вида колонии на чашке Петри. Иногда задействуют электронную микроскопию (просвечивающую или сканирующую) , постановку иммунологических реакций (гемагглютинацию, преципитацию в геле, и .т.п) , иммунохимическое окрашивание специфическими антительными препаратами и сыворотками с метками (иммунолюминесцентный анализ, иммуноферментный, радиоиммунный , хемилюминесцентный , и .т.д.)
Короче говоря , проводят кучу манипуляций , чтобы убедиться , что выделен именно чумной микроб, а не какой-то другой, и что именно он при введении его биопробным животным вызовет у них характерную картину заболевания и смерть в достаточно короткие сроки - от 24 до 120 часов.
С хорошо изученными вирусами (гриппа, оспы, и т.д.) примерно такая же метода : выделение, визуализация, получение чистой культуры, заражение животных , их болезнь и выделение чистой культуры уже от болеющих или переболевших животных.
А вот с вирусами, вызывающими СПИД , т.е. синдром приобретенного иммунодефицита , ситуация сложнее...
И эти сложности определяются двумя основными факторами : 1) возникновением иммунодефицитов у человека и животных после практически ЛЮБЫХ вирусных заболеваний 2) длительностью развития болезни.
И вот к чему это приводит.
Допустим у нас имеется "нулевой" пациент с выраженным иммунодефицитом, т.е. СПИД налицо. Начинаете брать анализы и пробы - находите в организме с полдюжины незнакомых вирусов : их -то в окружающей среде - пруд-пруди. Как же проверить то это или не то ? Биопробами проверить практически невозможно из-за сроков. Заразили сегодня , а клиническая картина иммунодефицита проявится через много лет , причем за эти годы подопытный может нахватать "с улицы" других вирусов, которые сами по себе вызывают иммунодефицит. И как же в этом случае узнать был ли первый вирус именно тем самым вирусом иммунодефицита ЧЕЛОВЕКА ? Да никак !
Практически ЛЮБОЙ вирус (тех же гепатитов, герпеса, разные вирусы гриппа, разные коронавирусы , и т.д.) могут привести к возникновению стойких прогрессирующих иммунодефицитов ) , что наглядно демонстрирует классификация ВИЧ в википедийной статье :ВИЧ-1
ВИЧ-1 описан в 1983 году и является наиболее распространённым и патогенным видом ВИЧ[87]. Глобальная эпидемия ВИЧ-инфекции главным образом обусловлена распространением ВИЧ-1. В подавляющем большинстве случаев, если не оговорено иначе, под ВИЧ подразумевают ВИЧ-1[88].
Вид ВИЧ-1 классифицируют на главную группу М и несколько побочных групп. Считается, что группы M, N, O, P образовались в результате независимых случаев передачи SIV от обезьяны к человеку, и последующей мутации вируса до ВИЧ[89].
Вирусы группы М (англ. main — основная) являются причиной более 90 % случаев ВИЧ-инфекции. Группу М классифицируют на несколько клад, называемых подтипами, также обозначаемых буквами:
подтип A широко распространён, например, в Западной Африке и России[90];
подтип B доминирует в Европе, Северной Америке, Южной Америке, Японии, Таиланде, Австралии[91];
подтип C преобладает в Южной и Восточной Африке, Индии, Непале, некоторых частях Китая[91];
подтип D обнаружен только в Восточной и Центральной Африке[91];
подтип E не был выявлен в нерекомбинантном виде, лишь совместно с подтипом А как CRF01_AE в Юго-Восточной Азии[91];
подтип F выявлен в Центральной Африке, Южной Америке и Восточной Европе[92];
подтип G и рекомбинантная форма CRF02_AG выявлены в Африке и Центральной Европе[92];
подтип H обнаружен только в Центральной Африке[92];
подтип I был предложен для описания штамма-продукта множественной рекомбинации CRF04_cpx нескольких подтипов[93];
подтип J распространён в Северной, Центральной и Западной Африке и странах Карибского бассейна[94];
подтип K обнаружен только в Конго и Камеруне[92].
подтип L обнаружен в Конго.[95]
Группа O (англ. outlier — непохожий) обнаружена в Центральной Африке и Западной Африке. Наиболее распространена в Камеруне, где в 1997 году более 2 % пациентов были заражены вирусом группы О[96] (около 100 000 человек, по данным на 2013 год)[97]. Вирусы этой группы не определялись ранними версиями тест-систем на ВИЧ-1; современные тесты определяют вирусы и группы О, и группы N[98].
Группа N (англ. non-M, non-O — ни M, ни O) обозначает штаммы не М и не О, описана в 1998 году и обнаружена только в Камеруне. С 2006 года выявлены лишь 10 заражений вирусами группы N[99].
Группа P — в 2009 году была определена нуклеотидная последовательность РНК ВИЧ, значительно сходная с вирусом иммунодефицита обезьян, описанным у горилл (SIVgor), но не с SIV, характерным для шимпанзе (SIVcpz). Вирус был выделен из образцов, полученных от женщины камерунского происхождения, проживающей во Франции[100][101][102].ВИЧ-2
ВИЧ-2 идентифицирован в 1986 году[103], генетически очень близок к T-лимфотропному вирусу SIVsmm мангабеев, и в меньшей степени к вирусу ВИЧ-1. Геномы ВИЧ-1 и ВИЧ-2 имеют гомологию консервативных генов gag и pol около 60 %, и до 45 % генов белков оболочки[104]. По состоянию на 2010 год, описано 8 групп ВИЧ-2, лишь группы A и B являются эпидемическими. Вирусы группы А распространены в Западной Африке, Анголе, Мозамбик, Бразилии, Индии и мало распространены в США и Европе[105][106]. Вирусы группы В распространены в Западной Африке
И что мы видим ? Два основных "вида" - ВИЧ-1 и ВИЧ-2, а внутри видов - десятки групп и подгрупп , вирусы которых отличны друг от друга !
Ну то есть мы имеем бездонную бочку с вирусами, из которых все более совершенствующимися методами идентификации, к которым в последние 30-40 лет добавились широко используемые молекулярно-биологические методы с установлением полной последовательности ДНК. Ну и соответственно , теперь , используя эти новые методические подходы, можно каждый год , каждый месяц и даже каждый день выявлять новые "уникальные" вирусы ,которые в той или иной степени будут вызывать у людей и животных иммунодефициты.
После чего проводить соответствующую пиар-кампанию и выбивать гранты и/или бюджетное финансирование на тот вирус "иммунодефицита" , который тебе удалось выделить и поддерживать в культуре. Соответственно появятся новые красивые фотографии, модели, картинки, новые отличающиеся между собой последовательности ДНК, и т.п.
https://venerolog-ginekolog.ru/wp-content/uploads/2020/04/как-вылядит-вич.jpg
https://avatars.mds.yandex.net/get-zen_doc/1634555/pub_5eed464f9d7f353d2390e3f0_5eed4e8d5738f05ea190bbd7/scale_1200
https://med-advisor.ru/wp-content/uploads/2017/01/Virus-immunodefitsita-cheloveka.jpg
https://www.linezolid.ru/wp-content/uploads/2017/05/1-18-1024x768.jpg
https://leganerd.com/wp-content/uploads/2014/05/hiv-virus-aids-magnified-1000.jpg
и т.д., и т.п.Бабки-то под это можно получить ... И получают ... Несхожесть результатов в разных руках можно будет объяснить либо появлением/открытием нового вида либо "мутацией" .
Под "новинку" можно за деньги наделать новых диагностикумов, вакцин, средств профилактики и лечения, и т.п.
И морочить всем этим голову обывателям и "власть+деньги"имущим до морковкиного заговения ....
Да можно с уверенностью сказать, что ВИЧ (вирусЫ иммунодефицита человека) существуют и приводят к серьезным осложнениям и смерти от других инфекций , с которыми самостоятельно справиться организм человека с иммунодефицитом не может. Но вот стратегия профилактики, а главное - лечения СПИД/ВИЧ вызывает у меня и многих моих коллег большие сомнения. Это скорее выглядит как проект обогащения фармацевтической и медицинской мафии, нежели вменяемая стратегия борьбы с напастью.
Примерно все то же самое можно сказать и о нынешнем коронавирусе с его мутантами. Да, он существует. Да, он может дать серьезные осложнения, Да он может убить.
Но что-то тут явно нечисто . Нашествия новых вирусных инфекций и массовых вирусных эпидемий стали регулярно трясти человечество именно после того, как развитие молекулярно-биологических методов позволило их СОЗДАВАТЬ в большом разнообразии.Достаточно взглянуть на хронологию , исключив из нее бактериальные инфекции : https://ru.wikipedia.org/wiki/Список_эп … и_пандемий
И особо внимательно взглянув на опасные и крупные эпидемии/пандемии после 1975 года , когда появились возможности вмешательства в структуру ДНК , сначала довольно грубые, а теперь - практически неограниченные : геном вируса можно сконструировать на бумаге/компьютере, а потом этот вирус с заданным геномом создать, синтезировав ДНК или РНК с заданной последовательностью.
Смотрим.
ОТ эпидемии испанского гриппа 1918-1920 до эпидемии азиатского H2N2 о прошло 40 лет
От азиатского до гонконского H3N2 - 20 лет
От гонконгского до "русского" (хотя хрен он "русский", это тот же гонконгский H3N2 , вероятно занесенный в СССР диверсионным путем) - 25 лет
А потом понеслось :
Грипп - 1995-1996
Лихорадка Марбурга - 1998-2000
SARS, SARS-CoV - 2002-2003
Птичий грипп, H5N1 -2004-2019
Грипп - 2004-2005
Свиной грипп, H1N1 - 2009-2010
Вирус Зика 2009Лихорадка Эбола 2014-2016
Вирус Зика 2015-2016
Лихорадка Эбола 2018-2020Коронавирус, COVID-19 - 2019-по настоящее время с многочисленными "мутациями"
К этому еще следует присовокупить вирусную африканскую чуму свиней, которой под эгидой Пентагона стала заниматься Грузия с 2004 года, и которая с 2007 года начала распространяться по югу России , особенно после поражения Грузии в войне 080808. Да еще вирусные гепатиты А и С , которым теперь занимаются в центре Лугара в Грузии и в трех лабораториях из 14 созданных на Украине.
В общем, "это ж-ж-ж - неспроста" (С).
Геномы возбудителей бактериальных инфекций устроены сложнее и морочиться с их созданием долго и дорого, а способы противодействия этим инфекциям - довольно хорошо разработаны
А вот конструировать вирусы с их простыми геномами на основе уже известных патогенных вирусов - проще. А лечение вирусных заболеваний разработано хуже.
Вот и появились, как грибы, сотни американских биологических лабораторий по всему миру , в которых в основном вирусными заболеваниями и занимаются, в полном нарушении Конвенции о биологическом оружии
И на кого эти лаборатории работают - на Пентагон или же на Гейтса с Соросом из кружка глобалистов - непонятно
Спасибо.
механик написал(а):Он о другом. Он про закредитованность. Она в России примерно 30 процентов от доходов граждан. То есть граждане закредитованы на 30 процентов своих максимальных возможностейпо выплатам. Есть мнение, что при нынешней, сложной экономической ситуации это уже близко к пределу.
При этом развитие самой ситуации не рассматривается. Закредитованность может уменьшаться, экономика, наоборот, развиваться, об этом разговора не было.
Было обычное, "Скоро вам хана! Путина геть!"
А Капри говорил, что есть мнение среди американцев, что жить в кредит -- это нормально.
Капри не обладал достаточным интеллектом, чтобы нести ответственность за свои слова.
Морозка написал(а):Да уж ладно.
В Калининграде даже в дальних поселках куча людей шастает. Бум покупок недвижимости... народ рванул из-за ковида отдыхать.А вообще, в Канаде куча мест без людей....... Там населения меньше, чем в России...
Интересно..... а в Австралии много деревень? Там всё-таки кенгуру есть.Канада и Австралия тоже при этом за охулиард рублей посылает актрис в космос киношку снимать?
Полет был на частные деньги. Главный спонсор банк Тинькофф. Ну и другие.
Юрий Лоза обвинил "киноэкипаж" в дискредитации профессии космонавта
Юрий Лоза обвинил съемочную группу фильма "Вызов" в дискредитации профессии космонавта
Музыкант и композитор Юрий Лоза - РИА Новости, 1920, 05.10.2021
© РИА Новости / Валерий Мельников
Перейти в фотобанк
МОСКВА, 5 окт - РИА Новости.
Российский певец Юрий Лоза раскритиковал съемочную группу фильма "Вызов", которая полетела на МКС, и задался вопросом, какие еще профессии в будущем будут дискредитированы "раскрученными дилетантами".
Во вторник на МКС прибыли космонавт Антон Шкаплеров, актриса Юлия Пересильд и режиссер Клим Шипенко. Киноэкипаж отправился на космическую станцию ради фильма "Вызов", который станет первой картиной в истории кинематографа со съемками профессиональных актеров в космосе.
Члены основного экипажа 66-й экспедиции на Международную космическую станцию актриса Юлия Пересильд, космонавт Антон Шкаплеров и режиссер Клим Шипенко перед стартом космического корабля Союз МС-19 - РИА Новости, 1920, 05.10.2021
"На Первом вовсю пиарят полет в космос нескольких актеров, не имеющих о космонавтике ни малейшего представления. Ранее медийные персонажи неумело танцевали со звездами паркета, выходили на сцены академических театров, плавали в бассейне с дельфинами, тусовались на манеже цирка и нарезали круги по льду (кстати, до сих пор нарезают) вместе с настоящими фигуристами. Я даже боюсь представлять – какие профессии будут дискредитированы в дальнейшем, и куда пригласят раскрученных дилетантов", – написал Лоза в посте в социальной сети "ВКонтакте".
По мнению артиста, современные деятели культуры ради пиара готовы "тушить пожары и вырезать аппендиксы", но им стоит оставить это для настоящих экспертов.
Лоза, известный своими критическими высказываниями в отношении всемирно известных музыкантов и композиторов, ранее вызвал большой резонанс заявлением и о космосе, сказав, что Юрий Гагарин, хоть и был "великим космонавтом", тем не менее "ничего не делал" и "просто лежал", "даже пальцем не мог пошевелить в первой капсуле".
Мероприятие в Исаакиевском соборе стало поводом для разбирательства
https://cdn-st1.rtr-vesti.ru/vh/pictures/xw/325/137/5.jpg
Министр обороны России Сергей Шойгу привлек к дисциплинарной ответственности военачальников Западного военного округа, по решению которых военнослужащих роты почетного караула направили для участия в церемонии венчания потомка династии Романовых.
"По данному факту проведено служебное разбирательство, в результате которого установлены нарушения отдельными должностными лицами требований руководящих документов. Привлечение военнослужащих роты почетного караула к мероприятиям регламентировано нормативными правовыми актами Минобороны", – цитирует РИА Новости источника в Минобороне.
Венчание потомка Романовых Георгия Михайловича и итальянки Ребекки Беттарини прошло в Исаакиевском соборе в Санкт-Петербурге 1 октября. У входа на торжество молодоженов встретили гвардейцы Преображенского полка.
Он к Романовым отношения не имеет.
Ещё при его рождении князь Василий Александрович Романов, председатель Объединения членов рода Романовых, опубликовал заявление, в котором говорилось: «Счастливое событие в прусском королевском доме не имеет отношения к Романовым, поскольку новорождённый князь не принадлежит ни к Русскому Императорскому дому, ни к роду Романовых»[2]. Рядом потомков Романовых по прямой мужской линии династические права Георгия Михайловича также оспариваются[3].
Обидно, для пруссака почетный караул подтянули.
Нет не посылает.
Они даже космонавтов послать не могут ни своих, ни не своих.
Тогда зачем себя с ними сравнивать?
Суникол написал(а):
ОК, после войны тоже было.. но заметь - никто эти деньги на запад не переводил в свои оффшоры.
Все шло на развитие а значит на пользу всем гномекам..Откуда же тогда взялись долги ангол, куб, вьетнамов и прочих северных корей?
Сам знаешь - от Хрущова с Брежневым. Не искали бы себе "друзей" было бы хуже.
Был ли другой путь? Не знаю. Если был опиши.
Суникол написал(а):
И где здесь долговая пирамида?
а пирамида тут причем?
было сказано
Суникол написал(а):
Что то я не помню чтобы после ВМВ в Европе кризисы были до его падения. Цвела и пахла..
Ответ - были.
Капитализм не может существовать без кризисов, такова его природа.
Зачем выдергивать пару слов и подменять ими тему? Мы с шуваловым говорили о долговых пирамидах
Отредактировано Суникол (2021-10-06 20:44:58)
Тогда зачем себя с ними сравнивать?
Как это зачем.....
Ну не с японцами же мне дедулю сравнивать. По сравнению с японцами этот дедуля -- миллиардер, ибо в его распоряжении целая деревня и куча полей разных

Oxigen_O2 написал(а):Можно и все процитировать. Но суть от этого не изменится.
Народ оттуда свалил на рубеже 70-х 80-х еще при советской власти, а дядя 57-ми лет отшельник, что-то у него не сложилось, о чем он сам "уклончиво объяснил", с тех пор не выезжая он говорит, что от Калининграда до Владивостока все живут как он, с 13-тью телятами, солнечными панелями, компьютером, трактором, и в рубищах.Отредактировано Oxigen_O2 (Сегодня 18:02:43)
Да я не про то. Что российская глубинка гниёт в нищете - ни разу не секрет. Меня именно разрыв вымораживает между супер-хайтеком в зомбоящике и спивающимися деревнями в стороне от федеральных трасс.
Опять же какая глубинка, она ведь не вся как под копирку. Вон можно спросить как живет глубинка староверов за Уралом, тут есть у кого.
Разрыв был всегда - его не может не быть. Быт якута, дагестанца, жителя Краснодара, помора, и обитателя в пределах Садового кольца очень отличался всегда. Вот во время царя и федеральных трасс с зомбоящиком не было а сухой закон вводили.
Проблема. Спиваться и не гнить не получится. И развивать просто необходимо коренные русские области, Дальний Восток и прочее.
Но кто то же сельское хозяйство все таки поднимает.
Шатун написал(а):Oxigen_O2 написал(а):Можно и все процитировать. Но суть от этого не изменится.
Народ оттуда свалил на рубеже 70-х 80-х еще при советской власти, а дядя 57-ми лет отшельник, что-то у него не сложилось, о чем он сам "уклончиво объяснил", с тех пор не выезжая он говорит, что от Калининграда до Владивостока все живут как он, с 13-тью телятами, солнечными панелями, компьютером, трактором, и в рубищах.Отредактировано Oxigen_O2 (Сегодня 18:02:43)
Да я не про то. Что российская глубинка гниёт в нищете - ни разу не секрет. Меня именно разрыв вымораживает между супер-хайтеком в зомбоящике и спивающимися деревнями в стороне от федеральных трасс.
Может он просто не вписался в рынок?
Точно. Всем селом еще в 70-е и 80-е. Потом он нашел в лесу солнечные панели, трактор, компьютер и коров с телятами, и к журналистам из навоза с лопатой вышел не в глаженном.
Наверно тоже спился а коровы с телятами сами себя доят и растут.
Морозка написал(а):Victor72 написал(а):То есть цифр не будет. Поздравляю Вас, господин соврамши.
https://minfin.gov.ru/ru/search/?q_4=внешний долг&source_id_4=6
Он о другом. Он про закредитованность. Она в России примерно 30 процентов от доходов граждан. То есть граждане закредитованы на 30 процентов своих максимальных возможностейпо выплатам. Есть мнение, что при нынешней, сложной экономической ситуации это уже близко к пределу.
При этом развитие самой ситуации не рассматривается. Закредитованность может уменьшаться, экономика, наоборот, развиваться, об этом разговора не было.
Было обычное, "Скоро вам хана! Путина геть!"
ПРоблема эта несколько преувеличена.
Домохозяйства "закредитованы" перед банками.
Банки в свою очередь получили деньги для кредитования домохозяйств либо от Центробанка либо от иностранных банков. То есть долги домохозяйств в неявном виде входят в корпоративный долг российских банков .
Корпоративный долг российских банков входит в общую сумму внешнего долга, который состоит из государственного долга и частного/корпоративного долга ( в основном это - займы российских банков и предприятий, взятых за рубежом) .
По данным Центробанка, по итогам первого полугодия 2020 г. общий объём внешнего долга России составил 481,5 млрд долл. Из этой суммы почти 55% пришлось на частный сектор, а 45% — на госсектор, в его расширенном понимании. (см. https://journal.open-broker.ru/economy/gosdolg-rossii )

Структура долга и его динамика изменения за последние 5 лет таковы :
То есть с 2015 года по 2020 год внешний долг сократился примерно на 75 млрд долларов : на 61 млрд - в государственном секторе , и на 14 млрд - в частном.
С этими долговыми обязательствами России несомненно следует соотнести величину ее золотовалютных резервов.
По данным Центробанка РФ (https://cbr.ru/statistics/macro_itm/svs/int-res/ ) международные резервы по состоянию на 24 сентября составили 617,9 млрд долларов США, сократившись за неделю на 1,9 млрд долларов США, или на 0,3%, под воздействием отрицательной переоценки, частично скомпенсированной покупкой иностранной валюты в рамках бюджетного правила.
Т.е. международные резервы РФ превышают ее общий государственный долг примерно на 28 % . Поэтому проблема может быть разрешена без особого напряга.
НО. В настоящий момент в этом нет никакого резона и смысла. Уже достаточно долгое время российские власти сохраняют такой баланс между долгом и зарубежными активами, чтобы в ответ на любой санкционный наезд на эти зарубежные российские активы с их замораживанием в порядке ответной меры заморозить отдачу внешнего долга на такую же или даже на бОльшую сумму.
Есть и еще один нюанс.
Долги домохозяйств не так-то просто востребовать : ни российским банкам, ни зарубежным кредиторам этих банков.
Затем востребованным долгом не так-то просто воспользоваться Ну скажем, домохозяйство закредитовалось на ипотеке, покупая недвижимость в собственность, и не потянуло долговую нагрузку . Ну и что дальше ?
Отберут квартиру ? Ну хорошо, и пусть отберут, если домохозяйство не справилось с этой проблемой. Дальше-то что ? Должник просто перейдет в съемное жилье , а суд присудит кредитору уплаченные должником деньги частично вернуть : проценты себе оставить, а уплаченные в погашение тела кредита деньги вернуть. Должнику этого на съемное жилье на какое-то время хватит. Возможно, что он в этой же самой квартире и останется на какое-то время. Кредиторам продать такие квартиры по-быстрому бывает весьма непросто.
Ну да ладно , это еще внутренние разборки - домохозяйства с российским банком-резидентом. А зарубежный банк-кредитор, который дал кредит российскому банку что может получить от этого банка? Увеличение своей доли в уставном капитале и доходах российского банка-резидента или же доведение его до банкротства ? Да и хрен с ним - пусть получает и пусть банкротит. Государство и население от этого особо не пострадают.
Ну и наконец, следует отметить, что накопления российских домохозяйств превышают долги российских домохозяйств. В отличие от многих "развитых стран"
БОНУС 1 https://www.kommersant.ru/doc/4918318
27.07.2021, 00:00
Человек копящийСбережения жителей России росли быстрее долгов даже в пандемию
Банк России опубликовал данные о сбережениях домохозяйств в структуре системы национальных счетов (СНС) — эти данные более сопоставимы с используемыми экономистами показателями сбережений, чем данные Росстата. Они подробно описывают крупные события на финрынке последних кварталов — быстрый рост финансовых активов при отстающем наращивании долга, увлечение граждан иностранным фондовым рынком, временный уход из депозитов и наличной валюты. Структура сбережений в РФ в этом схожа с рынками Польши и Греции и не сильно изменилась с 2018 года — накопления домохозяйств надежно превышают долги, пандемия тренда не изменила.
Данные ЦБ о сбережениях в терминологии СНС опубликованы впервые — это вычисления на основе данных платежного баланса, отчетности финрынка и секторальных балансов в СНС, в данном случае за первый квартал 2021 года (квартальные данные также есть за 2020 год, годовые оценки — за 2018–2020 годы). Публикация ЦБ дает возможность сопоставить с ними оценки сбережений и тренды сберегательного поведения домохозяйств в РФ в методологии Росстата, в которой из-за разницы в определениях возникает проблема с учетом вложений населения в иностранные активы. В определении СНС сбережения — это все, что осталось в домохозяйствах от доходов и не было истрачено на товары и услуги, это максимально широкое определение, позволяющее в том числе оценивать общее благосостояние домохозяйств.
Главный вывод, следующий из статистики ЦБ, для большинства населения (особенно без сбережений) неинтуитивен: с 2018 года домохозяйства продолжили накопления — несмотря на сильный рост кредита, финансовые активы в собственности граждан растут быстрее.
На начало 2018 года их размер составлял 76,7% ВВП, на конец первого квартала 2021-го — 95,4% ВВП: в начале года эти активы впервые превысили 100 трлн руб. и на 1 апреля оценивались в 105,5 трлн руб. Финансовые обязательства всех домохозяйств за то же время выросли с 17,4% до 22,8% ВВП. Эту тенденцию пандемия COVID-19 не изменила: по расчетам “Ъ”, прирост финактивов населения с апреля 2020 по апрель 2021 года составил 14,8 трлн руб., а прирост долгов — 3,6 трлн руб., не будет большим преувеличением говорить о «дополнительно отложенных» за пандемию домохозяйствами 11,2 трлн руб.: масштабное «разорение семей» из-за COVID-19 в масштабах экономики, «проедание сбережений» — видимо, миф.
В статистике ЦБ хорошо видны основные тренды с 2018 года — активное увлечение домохозяйств в России вложениями в иностранные акции и облигации при резком сокращении в конце 2020 года вложений в депозиты и в наличные деньги (как рубли, так и валюту): похоже, что быстрое распространение финансовой грамотности в крупных городах во время пандемии — не миф. Впрочем, преувеличивать масштабы этого не имеет смысла. При всем увлечении иностранными акциями и облигациями (в первом квартале 2021 года, напомним, они были выше, чем в российские) в нерезидентские инструменты в начале года «ушло» 697,3 млрд руб. (самые массовые вложения — в иностранные акции и паи инвестирующих в них фондов), в фининструменты резидентов — 256 млрд руб. (из депозитов «ушло» 827,6 млрд руб.). Но первый квартал — не слишком показательный период, стандартно в других кварталах домохозяйства больше вкладывают в рублевые инструменты. И наконец, эти цифры стоит сопоставить с объемом депозитов физлиц: это 35,1 трлн руб., треть всех сбережений.
Структура вложений домохозяйств довольно консервативна и мало отличается от ситуации 2018 года: она похожа на практику Греции и чуть меньше — Польши и Словакии, радикально отличаясь, например, от Турции и Венгрии.
Статистический «уход из депозитов» в 2020 году из-за падения доходности в длинном измерении все равно привел к росту объема вкладов населения.
Дмитрий Бутрин
Так что вожделенного Шуваловым финансового апокалипсиса в России не будет ... 
Вы здесь » Клуб Степняка » Куды бечь? Капитализм vs социализм » Куды бечь? Капитализм vs социализм, часть 46 #2